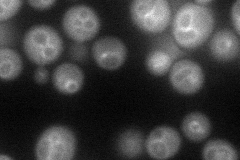
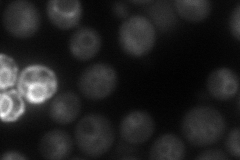
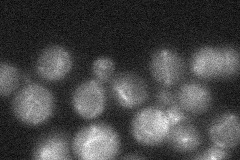
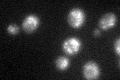

View description
Vacuolar membrane protein that is a subunit of the homotypic vacuole fusion and vacuole protein sorting (HOPS) complex; essential for membrane docking and fusion at the Golgi-to-endosome and endosome-to-vacuole stages of protein transport
Localization:
Intensity:
Fold change:
Significance:
-
C’ GFP library in SD

vacuole membrane24.28 -
N' NOP1pr-GFP in SD
vacuole membrane61.3177 -
N' TEF2pr-mCherry in SD
vacuole membrane63.5635 -
N' NATIVEpr-GFP in SD
vacuole membrane24.5676 -
N' TEF2pr-VC and Cyto-VN in SD

cytosol,punctate41.6312 -
C’ GFP library in SD+DTT
vacuole membrane21.840.89No -
C’ GFP library in SD+H2O2

vacuole membrane22.230.91No -
C’ GFP library in Starvation Media

punctateN/AN/AYes -
C’ GFP library on the background of Pup2-DaMP

vacuole membrane -
C’ GFP library on the background of CCT mutant

vacuole membrane18.45930.759974No
